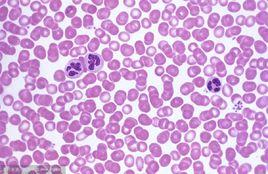
血塗片染色 血塗片染色

基本原理
瑞氏染色法原理
1、瑞氏染料是由酸性染料伊紅和鹼性染料美藍組成的複合染料。
美藍(又名亞甲藍mehyleneblue)為四甲基硫堇染料,有對醌型和鄰醌型兩種結構,通常為氯鹽,即氯化美藍,美藍容易氧化為一、二、三甲基硫堇等次級染料(即天青)市售美藍中部份已被氧化為天青。伊紅(又名曙紅cosin)通常為鈉鹽即伊紅化鈉。美藍和伊紅水溶液混合後產生一種憎液性膠體伊紅化美藍中性沉澱,即瑞氏染料。瑞氏染料溶於甲醇後,又重新解離為帶正電的美藍和帶負電的伊紅離子。
2、細胞的染色既有物理的吸附作用又有化學的親和作用。各種細胞和細胞的各種成份化學性質不同對各種染色料的親和力也不一樣。因此用染色液染色後在同一血片上可以看到各種不同的色彩,例如血紅蛋白嗜酸性顆粒為鹼性蛋白質與酸性染料伊紅結合染粉紅色稱為酸性物質,細胞核蛋白和淋巴細胞漿為酸性,與鹼性染料美藍或天青結合,染藍色或紫色稱為嗜鹼性物質,中性顆粒成等電狀態與伊紅和美藍均可結合,染紫紅色稱中性物質。
製作方法
血塗片 Wright’S染色法。①採血、制血膜、水平放置血膜片晾乾。②血膜片固定於甲醇 2~ 3min,取出晾乾。③用蠟筆在血膜片兩端劃一染色區,避免染色時染液外溢 。④往血膜片滴加瑞氏染液 (瑞氏染料 0.1g+甲醇 60m1),數十秒鐘後 ,再加一倍於染液的蒸餾水 ,染色 5~8min。⑤用磷酸緩衝液 (磷酸二氫鉀 6.63g+ 磷酸氫二鈉 2.56g+ 蒸餾水 1000m1)或蒸餾水輕輕沖洗血片,並不時鏡檢調色 ,至顏色合適為止。⑦血片晾乾後封固。結果顯示 :血細胞數量較多、分布均勻、形態結構典型、色澤和清晰度良好。
操作步驟
1、用毛細吸管吸取EDTA抗凝的外周血5-7UL,或者直接採集患者末梢血,將血滴滴至載玻片的一端約1CM處或整片的3/4端。有磨砂片的玻片,可在接近磨砂頭的部位來水反覆沖洗,然後擦乾備用。
2、左手持載玻片,右手持玻片,將推片接近血滴處,然後輕輕接觸血滴並壓在血滴上,使血液呈“ ̄”字型展開,充滿推片寬度。
3、將推片與載玻片形成30度夾角,用均勻的速度將血向載玻片的另一端推動。紅細胞壓積發生變化時,應適當的調整推片與載玻片的角度以及推動血液是的速度。標準的血塗片應做到頭、體、尾分明,兩邊和兩端留有空隙。
注意事項
①選用的玻片應潔淨乾爽、無污物潮濕 ,否則 ,有可能出現血片不潔、血細胞被玻片上的雜物損壞、以及 “潮濕”使血細胞著色產生偏差等不 良後果。
②血膜厚薄要適宜 ,太厚或太薄均不好 ,太厚不僅容易造成血細胞過多過密 、血膜片濃染 。而 日.,常會使部分 血細胞濃縮變小 、形態不佳 。太薄 ,血片的血細胞偏少 ,用於教學不理想 。每張血片的採血量約半粒黃豆大小為宜。推血片時,推片與血膜片約呈 45。夾角 ,這樣製成的血膜的厚薄較為合適。
③剛推好的、血液未乾的血膜片要水平放置晾乾。若此時直立放置 ,血液就會向下流動,很多血細胞就會跑到血液流向方血膜片一側的邊上 ,以至血膜片中央大部分 的血細胞數量相對減少。
④染色前 ,用甲醇將血膜片固定 ,能更好地保存血細胞的完好和完整,避免其變形、收縮和破碎 。
⑤注意製作方法中的三處 “晾乾”,否則 ,可能會產生血細胞著色不良、染色效果不好以及血片質量不佳等結果。
⑥封固血片,可更好 、更長時間保存之。封固劑通常選用 中性樹膠 ,我們嘗試用香柏油封固,發現其效果較好,血塗片更清晰、更不易褪色 ,但較難乾。